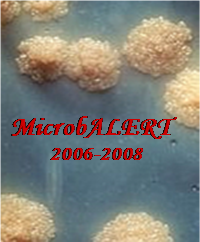

"NOI TEHNOLOGII DE OBTINERE A MICROBIOSENZORILOR PENTRU DETECTIA IN TIMP REAL SI MONITORIZAREA TUBERCULOZEI IN GRUPURI CU POTENTIAL DE RISC CRESCUT" |
|
|
|
Proiect complex finantat din Programul Cercetare de Excelenta (CEEX 2006), al Ministerului Educatiei si Cercetarii (MEdC) |